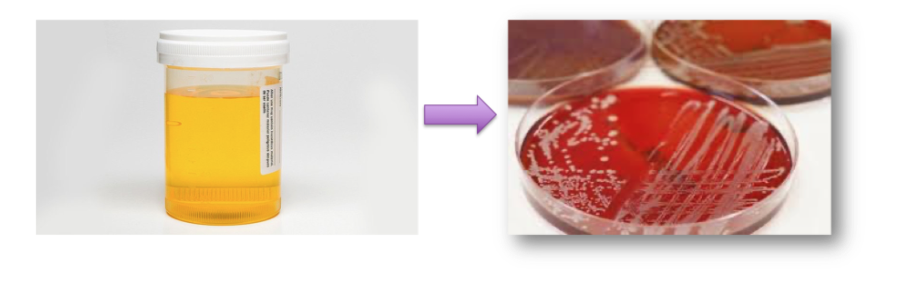

Does the presence of bacteria always lead to clinical signs?
no
subliclinical bacteriuria
a true urinary tract infection (and not a subclinical bacteriuria) is called
sporadic bacterial cystitis
How do we differentiate subclinical bacteriuria with sporadic bacterial cystitis?
bacteriuria
and
LUT clinical signs:
- pollakiuria
- stranguria
- haematuria
- dysuria
A patient with sporadic bacterial cystitis usually have how many episodes per year?
<3
does sporadic bacterial cystitis affect dogs or cats more commonly?
common in dogs
rare in cats
patients are otherwise healthy :)
What are host risk factors for UTI
- obesity
- female
- inability to void (neurological)
- urinary sphincter mechanism incompetence
- increasing age
- anatomical abnormalities of the urinary tract
- urolithiasis

What are the hosts defence mechanisms against UTI
- normal micturition
- anatomy of the UT
- mucosal defense (ie exfoliation of cells, GAG, exfoliation of cells)
- antimicrobial properties of urine (low or high ph, peptides, Lmw CHO)
- systemic immunity
what is recurrent bacterial cystitis?
> 3 times/ year
2 times/ year
will show clinical signs
Does urolithiasis predispose to bacterial infections?

yes
risk factors for bacterial UTI
- recent use of Ab
- catheterisation
- immunosuppression
- conditions resulting in dilute urine (DM, CKD)
- secondary to inflammation or trauma to UT
bacterial uropathogens are usually
commensals that infect via ascending infection
usually a single causative agent (90%)
What are the 4 most common uropathogens in SM?
- proteus
- E.Coli
- enterococcus
- CN staphylococcus
What are the most common uropathogens in LA?
same as SA
and Corynebacterium (can result in pyelonephritis)
How do bacteria persist in UTI?
- replicate within tissues
- Biofilm
How do you start your investigation on a UTI
- consider cx
- urinalysis
- definitive dx and tx based on quantitative urine culture
What is the most appropriate sample collection for urine for assessing UTI
- cystocentesis (gold standard)
- alternative option: aseptic catheterisation
can also perform cultures on:
- bladder biopsy
- cystolith
What is the least ideal sample collection for urine for assessing UTI
free catch
(sometimes this is the only method available, may need to follow up with a cystocentesis, consider difficulties in interpretation)
What does urinalysis not tell us about that we need to know for treatment
which antibiotic to use
What information is provided on a urinalysis
- SG: is urine concentrated?
- dipstick: proteinuria? hematuria? glucosuria?
- sediment
Does sporadic bacterial cystitis require further diagnostic investigation
no
Does recurrent bacterial cystitis require further diagnostic investigation
yes
What are the 1st line antimicrobials used for tx of sporadic bacterial cystitis?
- Amoxicillin
- TMPS
- (Amoxi-clav reasonable)
What does the sediment tell us?
- hematuria?
- pyuria (wbc)?
- crystalluria?
If a young cat has a suspected UTI should you do Culture?
YES, as it is rare for them to have bacterial UTI







































































































